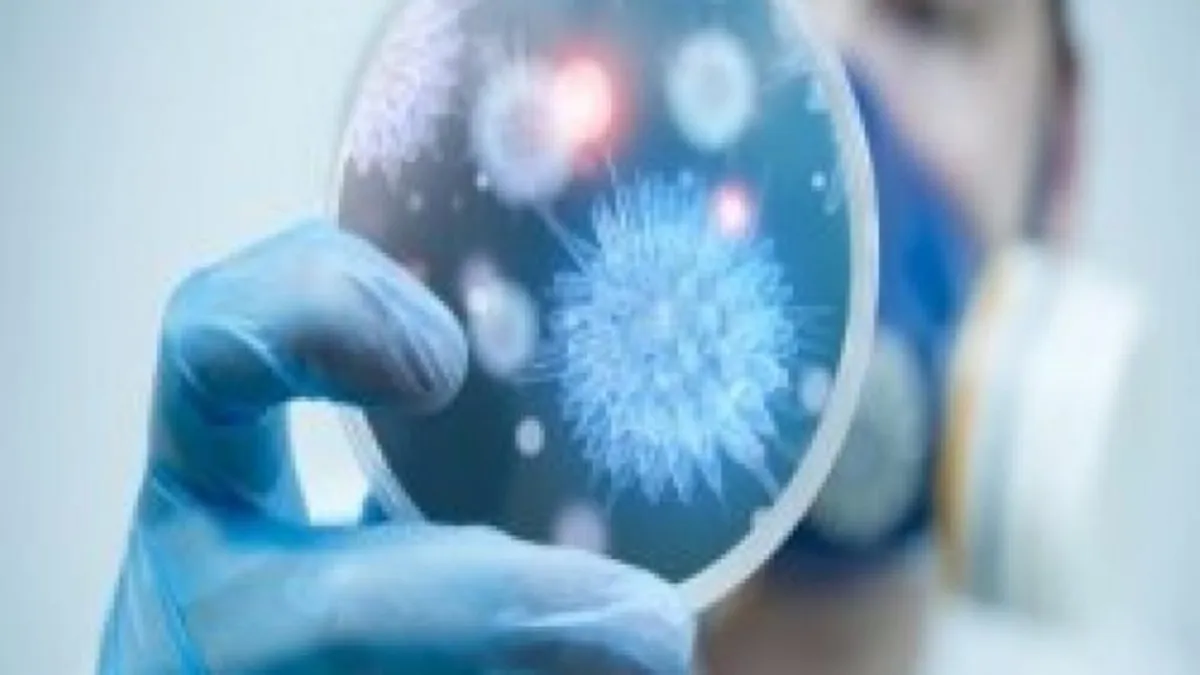

أطلقت وزارة البيئة والمياه والزراعة رسمياً أول جهاز "PCR" متنقل؛ وذلك بالحجر الحيواني والنباتي بمطار الأمير محمد بن عبدالعزيز في المدينة المنورة، بهدف الكشف عن 7 أمراض وفيروسات قاتلة.
وقال مدير الحجر الحيواني والنباتي في مطار المدينة وليد الرفاعي ، بحسب صحف محلية، أن الجهاز سيقوم بالكشف عن 7 أمراض هي "إنفلونزا الطيور، والحمى القلاعية، ومرض اللسان الأزرق، وطاعون المجترات، والحمى المالطية، وحمى الوادي المتصدع، وفيروس كورونا".
وأبان الرفاعي، أن الجهاز سيقلل من الوقت المُستخدم في عملية الكشف عن تلك الأمراض لتصبح ساعة واحدة بدلاً من يوم كامل، إلى جانب زيادة دقة نتائج التحليلات لتصل إلى نحو 93%.

Google News
Google News 


















